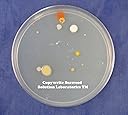
Thumbnail 4

Nutrient Agar Kit (Dehydrated) Lightning Fast FREE Shipping! (1-2 business days). HIGHEST QUALITY LABORATORY GRADE INGREDIENTS AVAILABLE Nutrient Agar is a microbiological growth medium commonly used for the routine cultivation of non-fastidious bacteria. It is useful because it remains solid even at relatively high temperatures. Also, bacteria grown in nutrient agar grows on the surface, and is clearly visible as small colonies. Kit Includes: *14 grams Nutrient Agar *20, 100mm x 15mm Petri Dishes with Lids 20 Sterile Cotton Swabs Instructions Each Kit will yield 600ml of Nutrient Agar Solution which will yield 20, 100mm Petri Dishes. FORMULA: 21.7% Pancreatic Digest of Gelatin (Peptone G) 13% Beef Extract 65.2% Agar Agar SOLUTION INSTRUCTIONS: Step 1: Dissolve Nutrient Agar in 600ml of Distilled Water Step 2: Bring Solution to a Boil Step 3: Autoclave at 121 degrees Celsius for 15 minutes Step 4: Allow to cool to 50 degrees Celsius Step 5: Pour into Petri Dishes Got a Question? Our staff Chemist would be happy to help! Just send us a note! Can't Find the Exact Agar Growth Media, quantity or kit you are Looking for? Let us know, perhaps we can help! FAQ: Q/ What is an autoclave and what is its purpose? A/ An autoclave is a device that heats the nutrient agar under pressure in order to sterilize it prior to inoculation. A household pressure cooker can be substituted for an autoclave provided it is capable of reaching 250 degrees Fahrenheit / 15 PSI. Note, many modern pressure cookers are not capable of reaching this temperature / pressure so make sure you check yours prior to using it as a autoclave. Q/ Is it absolutely necessary to sterilize the nutrient agar? A/ No. Sterilization is highly recommended but not required. Many would-be scientists have successful experiments without the use of an autoclave.
| ASIN | B00B79BD3Q |
| ASIN | B00B79BD3Q |
| Best Sellers Rank | #444,810 in Industrial & Scientific ( See Top 100 in Industrial & Scientific ) #239 in Lab Petri Dishes |
| Brand Name | Seaweed Solution Laboratories |
| Customer Reviews | 4.2 4.2 out of 5 stars (136) |
| Date First Available | October 1, 2012 |
| Is Discontinued By Manufacturer | No |
| Item Dimensions L x W | 3.94"L x 0.59"W |
| Item Volume | 600 Milliliters |
| Item Weight | 0.88 Pounds |
| Item model number | SG_B00B79BD3Q_US |
| Manufacturer | Seaweed Solution Laboratories |
| Manufacturer | Seaweed Solution Laboratories |
| Material | Cotton |
| Product Dimensions | 3.94 x 0.79 x 0.04 inches; 14.08 ounces |
| Sterile | Sterile |
| UPC | 609408017599 885348064378 |
| Unit Count | 1.0 Count |
A**R
Extremely Disappointing
If I could give less than a star I would. Package came on time, but the instructions stated to mix the powder with 700ml of water. I did this nearly 2 days ago now and I'm still waiting for it to set. Speaking to a friend who works with this stuff, she said that that is way too much water for the mixture. A complete waste of £70
Trustpilot
Hace 2 días
Hace 1 mes